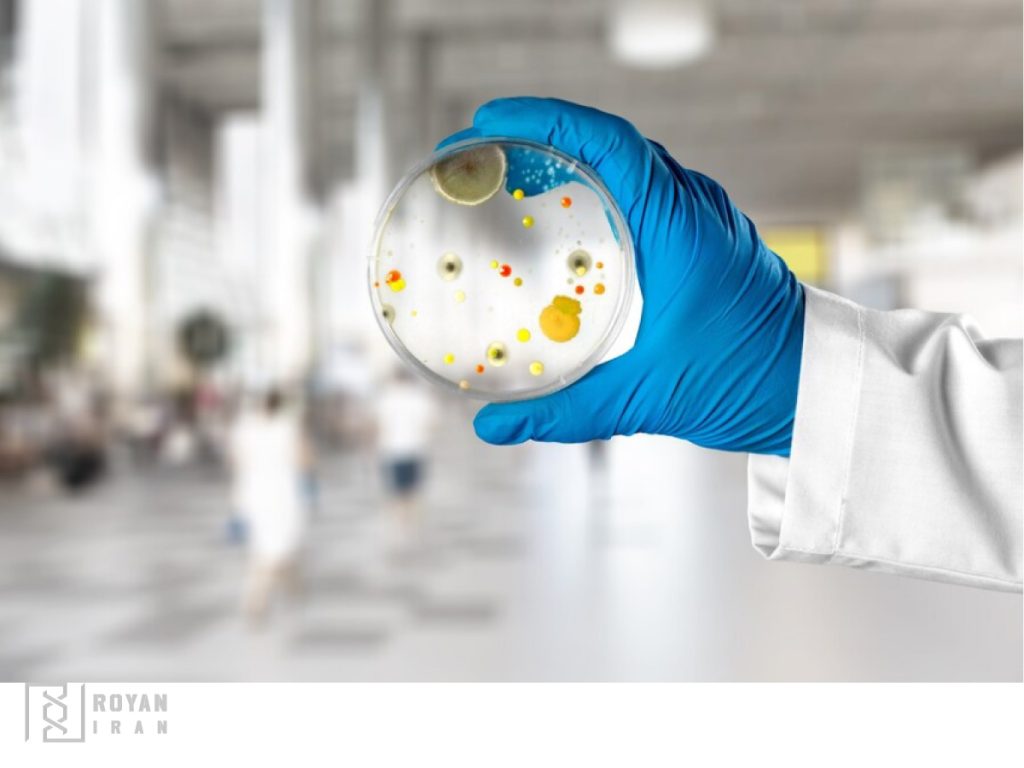
کشت میکروارگانیسم ها

انواع محیط های کشت
محیط کشت در واقع به موادی گفته می شود که میکروارگانیسم ها را می توان با استفاده از آن ها در شرایط آزمایشگاهی تکثیر و رشد داد. این محیط کشت است که به صورت بهینه مواد مغذی برای رشد و تکثیر میکروارگانیسم ها را فراهم می کند. همین محیط های کشت هستند که به پژوهشگران، پزشکان و صنایع مختلف مانند صنعت غذا و دارو، این امکان را می دهد که بتوانند آزمایش های مختلف انجام دهند. حتی بتوانند در آزمایشگاه های پزشکی بیماری های با منشاء باکتریایی یا قارچی را تشخیص دهند. محیط کشت یکی از مهم ترین مواد اولیه در اغلب آزمایشگاه های میکروبی و پزشکی است. رویان ایران، مرجع تخصصی فروش تجهیزات آزمایشگاهی، انواع محیط کشت ایبرسکو را با قیمت مناسب به فروش می رساند.
دراین پست، انواع محیط کشت ایبرسکو، بهترین برند محیط های کشت در ایران، را معرفی خواهیم کرد. در ادامه لیست قیمت به روز هر محیط کشت قابل مشاهده است. برای خرید محصولات با کارشناسان رویان ایران تماس حاصل کنید.

آشنایی با برند ایبرسکو
ایبرسکو یکی از معتبرترین برندهای ایرانی محیط کشت است. محصولات این برند بیش از دو دهه است که در آزمایشگاه های مختلف زیستی، میکروبی، پزشکی، دانشگاهی، پژوهشی، آب، صنایع غذایی، داروسازی، لبنیات و فراورده های آن، آرایشی و بهداشتی، نفت و پتروشیمی مورد استفاده قرار گرفته است.
انواع محیط کشت ایبرسکو طی سال های گذشته کیفیت در عملکرد خود را اثبات کرده اند. با اطمینان خاطر می توانید تمام محصولات این برند را خریداری کنید. زیرا این محیط های کشت همگی دارای استانداردهای ملی و بین المللی هستند.
انواع محیط کشت ایبرسکو
ایبرسکو با بیش از 250 نوع مختلف محیط کشت، تمام نیاز آزمایشگاه های مختلف برای کشت انواع باکتری، قارچ و مخمرها را برطرف می کند.
محیط های کشت ایبرسکو نسبت به نمونه های خارجی قیمت مناسب تر و کیفیت بالایی دارند. به همین دلیل رویان ایران، انواع محیط کشت ایبرسکو در حجم های 100 گرم و 500 گرمی با قیمتی کاملا مناسب عرضه می کند.
آیا رویان ایران فقط محیط های کشت باکتریایی ایبرسکو را عرضه می کند؟
ایبرسکو انواع محیط کشت های میکروارگانیسم ها برای کاربردهای مختلف شامل باکتری، قارچ و مخمرها را شامل می شود.

انواع محیط کشت ایبرسکو به چه صورت ارائه می شود؟
محیط های کشت در بسته بندی های 100 و 500 گرمی به صورت پودری عرضه می شوند. مطابق دستورالعمل روی بسته می توانید محیط کشت را در ظروف مخصوص کشت خود آماده کنید. برخی از محیط های کشت نیز به صورت آماده به فروش می رسند.

مدت زمان نگهداری محیط کشت چقدر است؟
بهتر است محیط کشت را قبل از انجام آزمایش آماده کنید و از نگهداری طولانی مدت آن ها خودداری نمایید. همچنین محیط های کشت را مطابق دستورالعمل روی بسته بندی در دمای 121 درجه سانتی گراد اتوکلاو قرار دهید.
نحوه آماده سازی انواع محیط کشت ایبرسکو چگونه است؟
شما از رویان ایران قوطی حاوی پودر انواع محیط کشت های ایبرسکو را دریافت می کنید. برای تهیه محیط کشت میکروبی، مطابق دستورالعمل روی بسته مقدار مشخصی از پودر را باید توزین و با آب مناسب آزمایشگاهی حل نمایید. بهتر است از دستگاه دیونایزر آزمایشگاهی برای تهیه آب مورد نیاز استفاده کنید.
پس از مخلوط کردن پودر محیط کشت با آب، آن را به مدت 15 دقیقه و در دمای 121 درجه سانتی گراد داخل اتوکلاو قرار دهید.
قیمت محیط کشت های ایبرسکو چقدر است؟
ایبرسکو بیش از 200 نوع محیط کشت مختلف برای کشت میکروبی دارد. با توجه به نوع محیط کشت و مقدار آن قیمت ها متفاوت است. قیمت ها از حدود 200 هزار تومان برای بسته های 100 گرمی شروع می شود که بسیار مقرون به صرفه است. انواع محیط کشت های ایبرسکو به همراه قیمت در فایل بالا قابل مشاهده است.
پس از انتخاب محیط کشت مورد نظر با کارشناسان رویان ایران تماس گرفته و محصول را در اسرع وقت در محل تحویل بگیرید.
چه تجهیزاتی برای کست میکروبی مورد نیاز است؟
- انواع تجهیزات مصرفی مانند پتری دیش های استریل
- هود لامینار
- انکوباتور
- اتوکلاو
رویان ایران تمام تجهیزات و دستگاه های ذکر شده را با بهترین قیمت عرضه می کند. برای خرید هود میکروبی سفارشی، انکوباتور، اتوکلاو و ظروف کشت با کارشناسان رویان ایران در تماس باشید.
خرید محصولات مصرفی آزمایشگاه SPL کره
خرید انواع محیط کشت ایبرسکو از رویان ایران با مناسب ترین قیمت
ایبرسکو بهترین برند ایرانی انواع محیط کشت است. محصولات این برند سال ها در انواع آزمایشگاه های تحقیقاتی و صنایع مختلف مورد استفاده قرارگرفته اند و کیفیت بالایی را نشان داده اند. رویان ایران، بزرگ ترین مرجع تخصصی فروش تجهیزات آزمایشگاهی، انواع محیط کشت ایبرسکو برای کشت، جداسازی و شناسایی میکروارگانیسم ها با قیمت مناسب عرضه می کند. فایل لیست قیمت به روز محیط کشت ایبرسکو در این پست قابل در این پست قابل دسترسی است. برای خرید محصولات این برند با بهترین قیمت همین حالا می توانید با شماره تلفن های 09128146417 و 02166971467 تماس حاصل نمایید. همچینین می توانید با شماره 09128146417 در شبکه های اجتماعی رویان ایران سفارش خود را ثبت نمایید.

